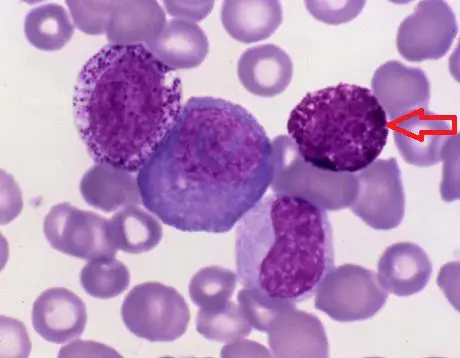
圖片描述

114年:(醫檢)血液(2)
下圖箭頭所指之細胞為何?
Abasophil
Beosinophil
Cneutrophil
Dmonocyte
詳細解析
本題觀念:
血液塗片中各類白血球(granulocytes vs agranulocytes)的辨識:根據胞質顆粒的染色性(acidic vs basic vs neutral dyes)、顆粒大小與分佈,以及核型特徵區分 neutrophil、eosinophil、basophil 與 monocyte。
影像分析:
從顯微鏡影像可見紅血球大小約 7–8 μm 作為比例尺,箭頭指向的細胞直徑約為 10–14 μm,胞質分布大量大小不一、深紫色至藍紫色顆粒,顆粒密集到幾乎完全遮蔽細胞核;核呈雙葉狀,但因顆粒遮蓋而不明顯。此種粗大並深染的顆粒為特徵性的嗜鹼性顆粒(basic granules),與中性粒細胞及嗜酸性粒細胞的顆粒染色性截然不同。
選項分析
- 選項A basophil
嗜鹼性粒細胞胞質充滿深藍至紫色的大顆粒,常遮蔽核形,核可呈雙葉或不規則形,但幾乎看不見;數量極少 (<1%),與題圖吻合(hematology.mlsascp.com)。 - 選項B eosinophil
嗜酸性粒細胞胞質顆粒大而均勻,呈紅橙色,核通常雙葉明顯;題圖顆粒非紅橙色,故排除(hematology.mlsascp.com)。 - 選項C neutrophil
中性粒細胞胞質顆粒小而分散,染成淡紫紅(lilac)或粉紅,核多分葉但顆粒不致完全遮蓋;題圖顆粒過大且深染,不符合(europepmc.org)。 - 選項D monocyte
單核球胞質灰藍色且無特化顆粒,核形可為腎形或馬蹄形,染色質稀疏;題圖顆粒明顯且深紫,與 monocyte 完全不同(hematology.mlsascp.com)。
答案解析
依胞質顆粒之染色性與大小判斷,只有 basophil 的顆粒會以 basic dyes 深染為紫藍色且密集遮蔽核型,符合題圖所見特徵,因此正確答案為選項 A(basophil)。
核心知識點
- 粒細胞分類:
‧ Neutrophil:specific granules 微小、淡紫/粉紅,核 2–5 片分葉。
‧ Eosinophil:granules 大、均勻、紅橙色,核雙葉。
‧ Basophil:granules 大、不規則、深藍/紫色,常掩蓋核。 - 顆粒染色原理:酸性染劑(eosin)對碱性組織成分(嗜酸性顆粒)呈紅色;鹼性染劑(methylene blue)對酸性組織成分(嗜鹼性顆粒)呈深藍至紫色;中性染劑對中性粒細胞顆粒呈淡紫。
- WBC 臨床意義:
‧ Basophilia:見於過敏反應、慢性骨髓增生性疾病(如 CML)。
‧ Eosinophilia:寄生蟲感染、過敏性疾病。
‧ Neutrophilia:細菌感染、急性發炎。
‧ Monocytosis:慢性感染、組織修復期。
臨床重要性
掌握白血球形態學是血液學診斷的基礎。在急慢性發炎、過敏反應或血液腫瘤疾病的臨床評估中,不同粒細胞與單核球的比例及形態變化具關鍵診斷價值。